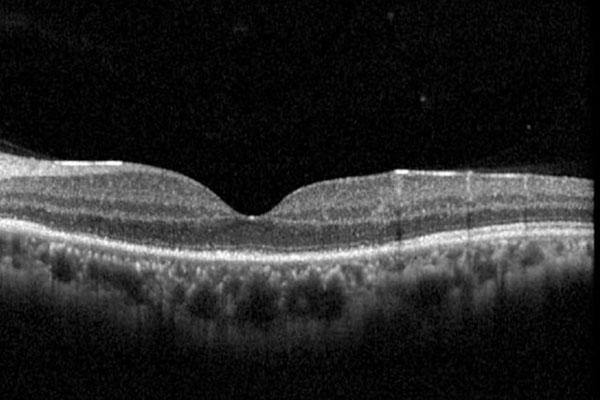

latest articles

Joint position statement: Strengthening eye screening for newborns and pre-schoolers in Malaysia
Shunmugam M., P., D., L., S., A., T., P., D., S., I., D., N., B., A., R., A., F., F., C., T., F., S., A., P., D., M., I., I., D., K., S., K., D., G., C., D. S. R.

Serum eye drops in treating recurrent corneal erosion syndrome
Nur Ain Syafira R., Muhammad Nazrin M. N.

Myopia: from refractive error to a public health challenge
Abdul Rahman N.

Short review of myopia and its impact in the COVID-19 era
Choo P., P., Bastion M.,-L., C., Mohd Abdullah A., A., Choo M., M., Choong Y., F., Ain Hussin D., Qamarruddin F., A Ami M., Muiz Mahyuddin M., Abdul Rahman N., Ramasamy S., Tang S., Y., Mohd Khialdin S.

Phthisis with a threat: imaging and histopathology of a ciliary body adenocarcinoma
Sai Priyalatha M., Gowri S., Wan Mohd Hafidz W., A., R., Bastion M.-L. C.

Local experience of concurrent three-weekly high-dose pulsed intravenous methylprednisolone and orbital radiotherapy in thyroid eye disease
Teoh R., J., J., Selvam R., Sumugam K., Syed Osman S., I., H., Bustamam R. S.
Posterior placoid chorioretinitis: a disguise of ocular syphilis
Low C., X., Zahari M., b., Abd Aziz R. A. b.

Ocular effects of Euphorbia trigona sap: a case report
Teoh C., Y., Ganasan D. K A/P

Is this really juvenile glaucoma?
Leng K., S., Lim J., J., Ng H. K.

Intralenticular foreign body: a case report
Sze Lian L., Wu Zhuan O., Hong Kee N.

Post-traumatic hypertensive filtering bleb: a rare presentation
Soundarajan V., T. Santhirathelagan C., Yusof N. S.






